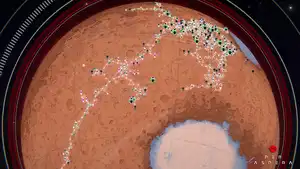

Per Aspera

Per Aspera
12+
В Per Aspera вы — ИИ, которому под силу сделать Марс новым домом для человечества. Превратите красную пустыню в цветущий мир, где бы вы ни были, благодаря GeForce NOW!
Об игре
В Per Aspera вы — ИИ, наделённый властью над целой планетой. Ваша задача: сделать Марс новым домом для человечества. Начните с малого и превратите красную пустыню в цветущий мир.
Per Aspera – это стратегия и симулятор колонизации, где вам предстоит исследовать новые технологии, строить города и руководить производством. Сумеете ли вы покорить суровый Марс?
- Управляйте целой планетой, используя нестандартные решения.
- Исследуйте огромный мир с уникальным рельефом и ресурсами.
- Играйте в Per Aspera где угодно с GeForce NOW — мгновенный запуск на любом устройстве.
Где купить
| Издатель | Raw Fury Games |
| Разработчик | Tlön Industries |
Особенности игры
| Keyboard | Доступно |
| Mouse | Доступно |